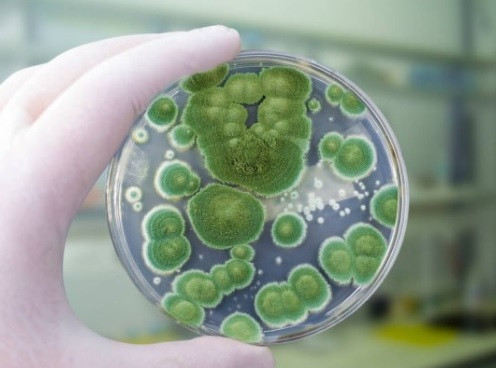
previewfullpenicillium.jpg

Mold is a common problem in residential and commercial buildings. It thrives in damp and moist conditions, such as in recently flooded or water-damaged areas. The increase in moisture caused by possible severe weather increases the likelihood of mold growth indoors.
Mold and mildew are often used interchangeably, but there's a difference between the two. Discover mold and mildew prevention tips and the difference between the two with Armstrong Water Mold Cleanup.
Mold and mildew are often used interchangeably, but there's a difference between the two. Discover mold and mildew prevention tips and the difference between the two with Armstrong Water Mold Cleanup.
What is Mold?
Mold is a term for microscopic fungi that live on organic matter. Mold comes in different species and different colors, usually green or black. It penetrates the surfaces it grows on which makes removal difficult.
The most common types of indoor mold are:
The most common types of indoor mold are:
Aspergillus
- Aspergillus is a common indoor mold that can reach maturity in as little as three days.
- Appears white at first then gradually turns into yellow, green, brown or black.
- Aspergillus can cause infections and respiratory issues, such as Aspergillosis.
Cladosporium
- Cladosporium appears olive-green or brown.
- Commonly found growing on plant material, carpets, bathrooms and HVAC systems.
- Cladosporium can cause eye, nose, throat and skin irritation and trigger asthma.
- Cladosporium appears olive-green or brown, commonly found growing on plant material.
- This type of mold is commonly found on carpets, bathrooms and HVAC systems.
- Cladosporium can cause eye, nose, throat and skin irritation and trigger asthma.
Penicillium
- Often appears in shades of green, blue or sometimes white and grows in cool, damp environments.
- Penicillium is commonly found growing on decaying organic material in nature. Indoors, it develops on building materials such as wood and tile.
- Penicillium can cause infections and allergic reactions to people with compromised immune systems.
What is Mildew?
Mildew is a non-penetrative fungus that grows on surfaces and can easily be wiped away. Mildew is white in color and is characterized by a flat growth often seen on the leaves of plants. Like mold, mildew grows in areas of high moisture or on damp surfaces.
How to Prevent Mold and Mildew Growth
- Regularly inspect your property for signs of water damage. In as little as 24 to 48 hours after a water damage incident, mold can start developing.
- Control humidity levels - keep it to about 40 to 50 percent.
- Fix leaks as soon as they are noticed.
- Schedule routine HVAC system inspections and cleanings.
- Ensure proper ventilation, especially in damp places like bathrooms.
- Remove plants affected by mildew as soon as they are noticed.
Schedule a Mold Remediation Appointment Today

Armstrong Water Mold Cleanup and Restoration has been restoring residential and commercial properties after mold damage since 2005. We offer quality service, affordable pricing and guaranteed satisfaction.
- IICRC-Certified in Water Damage Restoration, Applied Structural Drying, Fire & Smoke Restoration and Applied Microbial Remediation (#100623)
- Lead Safe Certified by the US Environmental Protection Agency (#NAT-F155753-1, issued 7-10-2015)
- We work directly with insurance companies to maximize the covered benefits for property restoration.
- We offer FREE inspections and estimates and respond in 2 hours or less.
To discover more about mold and mildew remediation, call Armstrong Water Mold Cleanup and Restoration at (239) 592-3777 or connect with us online today.